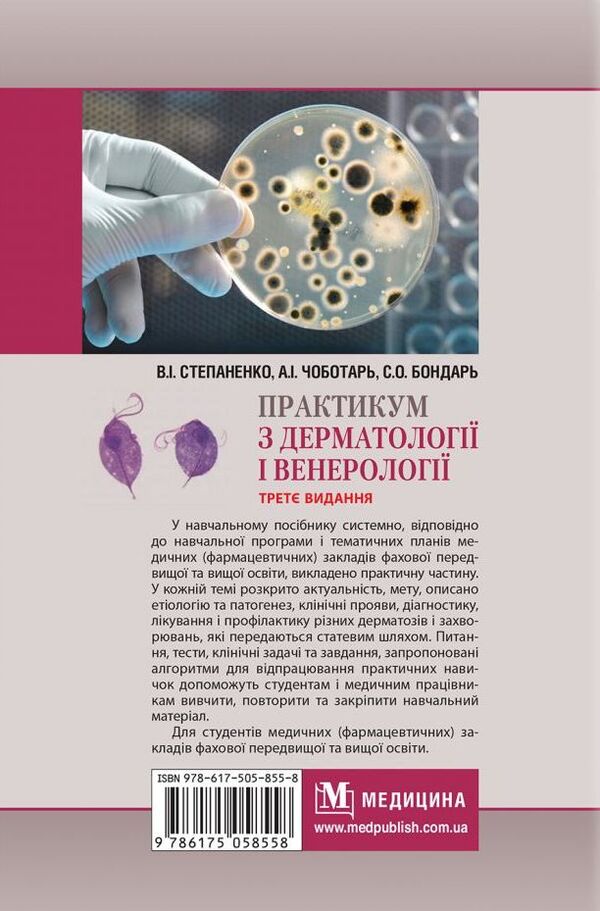
Workshop on dermatology and venereology / Практикум з дерматології і венерології Виктор Степаненко, Светлана Бондарь, Анатолий Чоботарь 978-617-505-855-8-3

Практикум з дерматології і венерології. Workshop On Dermatology And Venereology
Практикум з дерматології і венерології. Workshop On Dermatology And Venereology
Couldn't load pickup availability
Share
Author
Author
Viktor Stepanenko, Svetlana Bondar, Anatoly Chobotar / Віктор Степаненко, Світлана Бондар, Анатолій Чоботар
Dimension
Dimension
150x220mm (5,9'x8,7')
ISBN
ISBN
9786175058558
Format
Format
Hardcover
Language
Language
Ukrainian
Page Count
Page Count
360
Publisher
Publisher
Медицина
Year of book publication
Year of book publication
2021
Практикум з дерматології і венерології. Workshop On Dermatology And Venereology
У навчальному посібнику системно, відповідно до навчальної програми і тематичних планів медичних (фармацевтичних) закладів фахової передвищої та вищої освіти, викладено практичну частину. У кожній темі розкрито актуальність, мету, описано етіологію та патогенез, клінічні прояви, діагностику, лікування і профілактику різних дерматозів і захворювань, які передаються статевим шляхом. Питання, тести, клінічні задачі та завдання, запропоновані алгоритми для відпрацювання практичних навичок допоможуть студентам і медичним працівникам вивчити, повторити та закріпити навчальний матеріал.
Для студентів медичних (фармацевтичних) закладів фахової передвищої та вищої освіти.SPECIFICATIONS:
Author:Viktor Stepanenko, Svetlana Bondar, Anatoly Chobotar - Віктор Степаненко, Світлана Бондар, Анатолій Чоботар
Publisher:Медицина
Language:Ukrainian/Українська
Publication Date:2021
Number of pages:360 pst
Format:Hardcover
Width:150 mm / 5,9'
Height:220 mm / 8,7'
Weight:500 g
Illustrations:Black and white
ISBN:9786175058558